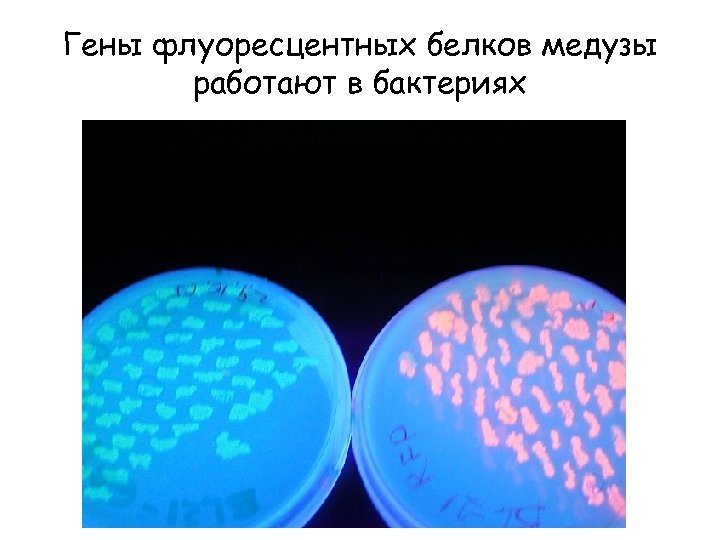
Гены флуоресцентных белков медузы работают в бактериях

29129a653e13b1d4c5ab35a403b76c1b.ppt
- Количество слайдов: 55
 Лекция 10 Геном Лекция 9 Плазмиды 103 - 104 Вирусы 103 - 104 Митохондрии и Хлоропласты - 104 - 105 ПРОКАРИОТЫ - 105 - 106 ЭУКАРИОТЫ Дрожжи 107 Животные 108 - 109 Растения 109 - 1011 2 500 знаков/стр, 400 стр/книгу 106 знаков/книгу
Лекция 10 Геном Лекция 9 Плазмиды 103 - 104 Вирусы 103 - 104 Митохондрии и Хлоропласты - 104 - 105 ПРОКАРИОТЫ - 105 - 106 ЭУКАРИОТЫ Дрожжи 107 Животные 108 - 109 Растения 109 - 1011 2 500 знаков/стр, 400 стр/книгу 106 знаков/книгу
 Автоматическое секвенирование Определение первичной структуры ДНК In January 2012, Life Technologies introduced a sequencer to decode a human genome in one day for $1, 000
Автоматическое секвенирование Определение первичной структуры ДНК In January 2012, Life Technologies introduced a sequencer to decode a human genome in one day for $1, 000
 Автоматический синтез ДНК
Автоматический синтез ДНК
 Гибридизационная диагностика генов с флуоресцентными метками Анализ на хромосомах Массовый анализ на микрочипах
Гибридизационная диагностика генов с флуоресцентными метками Анализ на хромосомах Массовый анализ на микрочипах
 С 2000 по 2009 гг число людей, живущих с ВИЧ в Восточной Европе и Центральной Азии, увеличилось почти в три раза. В 2009 г, по оценкам, это число достигло 1, 4 млн чел (т. е. 1 из неск 100), в 2000 г оно было 0, 53 В мире насчитывается от 31 до 35 миллионов ВИЧинфицированных
С 2000 по 2009 гг число людей, живущих с ВИЧ в Восточной Европе и Центральной Азии, увеличилось почти в три раза. В 2009 г, по оценкам, это число достигло 1, 4 млн чел (т. е. 1 из неск 100), в 2000 г оно было 0, 53 В мире насчитывается от 31 до 35 миллионов ВИЧинфицированных
 Получение ДНК Полимеразная цепная реакция (ПЦР) Кэрри Маллис Нобелевская премия по химии 1993 г.
Получение ДНК Полимеразная цепная реакция (ПЦР) Кэрри Маллис Нобелевская премия по химии 1993 г.
 AAAAA Oligo d. T primer is bound to m. RNA RT TTTTT RT Reverse transcriptase (RT) copies first c. DNA strand AAAAA TTTTT RT Reverse transcriptase digests and displaces m. RNA and copies second strand of c. DNA Double strand c. DNA Копирование м. РНК в к. ДНК обратной транскриптазой
AAAAA Oligo d. T primer is bound to m. RNA RT TTTTT RT Reverse transcriptase (RT) copies first c. DNA strand AAAAA TTTTT RT Reverse transcriptase digests and displaces m. RNA and copies second strand of c. DNA Double strand c. DNA Копирование м. РНК в к. ДНК обратной транскриптазой
 50º A. Double strand DNA 96º B. Denature 50º C. Anneal primers Taq 72º D. Polymerase binds Taq
50º A. Double strand DNA 96º B. Denature 50º C. Anneal primers Taq 72º D. Polymerase binds Taq
 Taq 72º Taq E. Copy strands Taq 1 96º First round of c. DNA synthesis (4 strands) 2 3 4 F. Denature
Taq 72º Taq E. Copy strands Taq 1 96º First round of c. DNA synthesis (4 strands) 2 3 4 F. Denature
 1 2 G. Anneal primers 50º 3 4
1 2 G. Anneal primers 50º 3 4
 1 Taq 72º Taq 2 3 Taq 4 H. Polymerase binds
1 Taq 72º Taq 2 3 Taq 4 H. Polymerase binds
 1 Taq 72º 2 Taq I. Copy strands 3 Second round of c. DNA synthesis (8 strands) Taq 4
1 Taq 72º 2 Taq I. Copy strands 3 Second round of c. DNA synthesis (8 strands) Taq 4
 1 J. Denature at 96º Anneal primers at 50º 2 3 4
1 J. Denature at 96º Anneal primers at 50º 2 3 4
 1 72º K. Bind polymerase (not shown) and copy strands 2 Third round of c. DNA synthesis (16 strands) 3 4
1 72º K. Bind polymerase (not shown) and copy strands 2 Third round of c. DNA synthesis (16 strands) 3 4
 1 L. Denature at 96º Anneal primers at 50º 2 3 4
1 L. Denature at 96º Anneal primers at 50º 2 3 4
 1 72º M. Copy strands at 72º 2 3 Fourth round of c. DNA synthesis (32 strands) 4
1 72º M. Copy strands at 72º 2 3 Fourth round of c. DNA synthesis (32 strands) 4
 1 c. DNA strands (32) are now shown as lines 2 3 4
1 c. DNA strands (32) are now shown as lines 2 3 4
 1 After 5 rounds there are 32 double strands of which 24 (75%) are same size 2 3 4
1 After 5 rounds there are 32 double strands of which 24 (75%) are same size 2 3 4
 Эндонуклеазы рестрикции II (рестриктазы) гидролизуют ДНК по определенным участкам
Эндонуклеазы рестрикции II (рестриктазы) гидролизуют ДНК по определенным участкам
 Полиморфизм длины рестрикционных фрагментов (ПДРФ)
Полиморфизм длины рестрикционных фрагментов (ПДРФ)
 Полиморфизм длины рестрикционных фрагментов Сэр Алек Джеффрис, 1985 (ПДРФ)
Полиморфизм длины рестрикционных фрагментов Сэр Алек Джеффрис, 1985 (ПДРФ)
 Дактилоскопия ДНК Идентификация личности Идентификация родства Идентификация царской семьи Инцест Египетских фараонов Кто была Ева и откуда она Неандертальцы и Homo sapiens Полиморфизм тандемных повторов (STR) 1998 CODIS: Combined DNA Index System
Дактилоскопия ДНК Идентификация личности Идентификация родства Идентификация царской семьи Инцест Египетских фараонов Кто была Ева и откуда она Неандертальцы и Homo sapiens Полиморфизм тандемных повторов (STR) 1998 CODIS: Combined DNA Index System
 Где родилась Ева? В Мемфисе, Вавилоне или Мохенджо-Даро? В Мемфисе, Африка
Где родилась Ева? В Мемфисе, Вавилоне или Мохенджо-Даро? В Мемфисе, Африка
 Рекорды дактилоскопии ДНК 2006 г. идентификация ДНК через 33 тыс лет
Рекорды дактилоскопии ДНК 2006 г. идентификация ДНК через 33 тыс лет
 Что такое клонирование? Клон – генетически идентичное потомство одной клетки (одного организма) Клонирование: - живого объекта (организма, клеток), - неживого объекта (ДНК) – жаргон!
Что такое клонирование? Клон – генетически идентичное потомство одной клетки (одного организма) Клонирование: - живого объекта (организма, клеток), - неживого объекта (ДНК) – жаргон!
 КЛОНИРОВАНИЕ – точное воспроизведение живого объекта в нескольких копиях. . . Все «копии» должны обладать идентичной наследственной информацией, т. е. нести идентичный набор генов. Генетики получают клоны размножением партеногенезом, т. е. бесполым путем, без предшествующего оплодотворения. Естественное клонирование человека – феномен однояйцевых близнецов. Л. И. Корочкин Клонирование ДНК – жаргон!
КЛОНИРОВАНИЕ – точное воспроизведение живого объекта в нескольких копиях. . . Все «копии» должны обладать идентичной наследственной информацией, т. е. нести идентичный набор генов. Генетики получают клоны размножением партеногенезом, т. е. бесполым путем, без предшествующего оплодотворения. Естественное клонирование человека – феномен однояйцевых близнецов. Л. И. Корочкин Клонирование ДНК – жаргон!
 Не путать с “Репродуктивной медициной” ЭКО 25 июля 1978 г. Louise Brown 30 лет – 4 млн The Nobel Prize in Physiology or Medicine 2010 Robert G. Edwards University of Cambridge, UK "for the development of in vitro fertilization”
Не путать с “Репродуктивной медициной” ЭКО 25 июля 1978 г. Louise Brown 30 лет – 4 млн The Nobel Prize in Physiology or Medicine 2010 Robert G. Edwards University of Cambridge, UK "for the development of in vitro fertilization”
 Не путать с “Пре-имплантационной диагностикой и естественным терапевтическим “клонированием” Клетки НЕ разбирают на компоненты и детей НЕ убивают! Молли и Адам Нэш с родителями окт. 19, 2000 авг (рожд) Естественное выращивание генетически недефектного брата (сестры) для пересадки органа (костный мозг) генетически дефектному родственнику
Не путать с “Пре-имплантационной диагностикой и естественным терапевтическим “клонированием” Клетки НЕ разбирают на компоненты и детей НЕ убивают! Молли и Адам Нэш с родителями окт. 19, 2000 авг (рожд) Естественное выращивание генетически недефектного брата (сестры) для пересадки органа (костный мозг) генетически дефектному родственнику
 Пересадка ядер и клонирование “Don’t clone humans!” Science 2001, 291, 2552
Пересадка ядер и клонирование “Don’t clone humans!” Science 2001, 291, 2552
 Цикл III Генотип и фенотип 8. Регуляция, передача сигнала (рак) 9. Геном, плазмиды, вирусы (ВИЧ) 10. Генетическая инженерия (ГМО)
Цикл III Генотип и фенотип 8. Регуляция, передача сигнала (рак) 9. Геном, плазмиды, вирусы (ВИЧ) 10. Генетическая инженерия (ГМО)
 Дополнительная литература www. issep. rssi. ru
Дополнительная литература www. issep. rssi. ru
 Конструирование рекомбинантных ДНК
Конструирование рекомбинантных ДНК

 Генная инженерия 4/5 основных этапа In vitro (в пробирке) 1. 1. Получение генов (ПЦР) 2. 1’. Выбор вектора 2. Получение рекомбинантных ДНК In vivo (в клетке) 3. Введение рек. ДНК в клетку (трансформация) 4. Отбор целевых клеток (скрининг) Библиотеки генов
Генная инженерия 4/5 основных этапа In vitro (в пробирке) 1. 1. Получение генов (ПЦР) 2. 1’. Выбор вектора 2. Получение рекомбинантных ДНК In vivo (в клетке) 3. Введение рек. ДНК в клетку (трансформация) 4. Отбор целевых клеток (скрининг) Библиотеки генов
 Этап 1. Получение ДНК Полимеразная цепная реакция (ПЦР) Кэрри Маллис Нобелевская премия по химии 1993 г.
Этап 1. Получение ДНК Полимеразная цепная реакция (ПЦР) Кэрри Маллис Нобелевская премия по химии 1993 г.
 Этап 2. Векторная ДНК
Этап 2. Векторная ДНК
 Вектор для прокариот
Вектор для прокариот
 Получение рекомбинантных ДНК
Получение рекомбинантных ДНК
 Искусственная мини-хромосома Стрелка показывает на искусственную мини-хромосому, которая функционирует как натуральная (голубая) Может служить мега-вектором для клонирования ДНК
Искусственная мини-хромосома Стрелка показывает на искусственную мини-хромосому, которая функционирует как натуральная (голубая) Может служить мега-вектором для клонирования ДНК
 Этап 3. Трансформация введение ДНК в клетку Физические: Микроинъекция Электропорация Эндоцитоз Биобаллистика (W, Au – 0, 1 мкм) Химические: - Ca 2+ Слияние мембран: Липосомы Рецепторный Рекомбинантные вирусы (? ) - Аденовирус - Герпеса - ВИЧ
Этап 3. Трансформация введение ДНК в клетку Физические: Микроинъекция Электропорация Эндоцитоз Биобаллистика (W, Au – 0, 1 мкм) Химические: - Ca 2+ Слияние мембран: Липосомы Рецепторный Рекомбинантные вирусы (? ) - Аденовирус - Герпеса - ВИЧ
 Этап 4 «Клонирование ДНК»
Этап 4 «Клонирование ДНК»
 ИДЕНТИФИКАЦИЯ КЛОНОВ с рекомбинантной ДНК при помощи зонда
ИДЕНТИФИКАЦИЯ КЛОНОВ с рекомбинантной ДНК при помощи зонда
Гены флуоресцентных белков медузы работают в бактериях
Гены флуоресцентных белков медузы работают в бактериях
 Трансгенные организмы (ГМО, ГМП) Цель введения нового гена в клетку: - Замена дефектного гена для восстановления функции - Новый ген для изменения фенотипа (новые свойства) - Новый ген для продукции новых веществ (клеточные фабрики или фабрики - организмы) Делеция гена в клетке - Генетический нокаут (ДНК) - Генетический нокдаун (м. РНК)
Трансгенные организмы (ГМО, ГМП) Цель введения нового гена в клетку: - Замена дефектного гена для восстановления функции - Новый ген для изменения фенотипа (новые свойства) - Новый ген для продукции новых веществ (клеточные фабрики или фабрики - организмы) Делеция гена в клетке - Генетический нокаут (ДНК) - Генетический нокдаун (м. РНК)
 Рекомбинантные белки, разрешенные для лечения человека БЕЛОК Вакцины Моноклональные антитела Антигемофильный фактор Гормон роста ДНКаза I Инсулин Интерлейкин Интерфероны Тканевый активатор плазминогена (тромболитик) Эритропоэтин ЗАБОЛЕВАНИЕ Гемофилия Дефицит у детей Муковисцидоз Сахарный диабет Рак почки Множественный эффект Острый инфаркт миокарда Острая обширная эмболия легочной артерии Анемия, заболевания почек
Рекомбинантные белки, разрешенные для лечения человека БЕЛОК Вакцины Моноклональные антитела Антигемофильный фактор Гормон роста ДНКаза I Инсулин Интерлейкин Интерфероны Тканевый активатор плазминогена (тромболитик) Эритропоэтин ЗАБОЛЕВАНИЕ Гемофилия Дефицит у детей Муковисцидоз Сахарный диабет Рак почки Множественный эффект Острый инфаркт миокарда Острая обширная эмболия легочной артерии Анемия, заболевания почек
 Получение трансгенных растений устойчивость к неблагоприятным факторам и полезные потребительские свойства
Получение трансгенных растений устойчивость к неблагоприятным факторам и полезные потребительские свойства
 Получение трансгенных животных
Получение трансгенных животных

 Гены флуоресцентных белков медузы работают в животных Химера из белка клетки (раковый белок) и флуоресцентного белка
Гены флуоресцентных белков медузы работают в животных Химера из белка клетки (раковый белок) и флуоресцентного белка
 Нобелевская премия по химии 2008 Osamu Shimomura Martin Chalfie for the discovery and development of the green fluorescent protein, GFP Roger Y. Tsien
Нобелевская премия по химии 2008 Osamu Shimomura Martin Chalfie for the discovery and development of the green fluorescent protein, GFP Roger Y. Tsien
 Генотерапия замена дефектного гена на нормальный Только: соматические клетки конкретного пациента
Генотерапия замена дефектного гена на нормальный Только: соматические клетки конкретного пациента
 Генотерапия 14. 09. 1990 Бетезда, НИЗ, США дефект аденозиндезаминазы (иммунодефицит)
Генотерапия 14. 09. 1990 Бетезда, НИЗ, США дефект аденозиндезаминазы (иммунодефицит)
 Генетический контроль и биологическая безопасность Межведомственная комиссия по проблемам генноинженерной деятельности МВКГИД (www. iacgea. ru)
Генетический контроль и биологическая безопасность Межведомственная комиссия по проблемам генноинженерной деятельности МВКГИД (www. iacgea. ru)

 • • • • • • • • История важнейших открытий 1901 - Ландштейнер открыл группы крови, начало переливания крови 1906 - первая пересадка трупной роговицы 1910 - Томас Морган открыл хромосомы - органеллы наследственности 1926 - Меллер открыл мутагенные эффекты радиации и химических веществ 1912 - Бантинг и Бест открыли инсулин и причину диабета 1936 - первые ферменты получены в кристаллическом состоянии 1944 - Осваль Эвери и Маклин Мак. Карти доказали, что изолированная ДНК встраивается в геном бактерий, изменяя их фенотип 1904 - Нобелевская премия в области физиологии и медицины присуждена Ивану Петровичу Павлову за открытие условных рефлексов 1951 - первая операция коронарного шунтирования (коронарный байпасс) 1953 - Джеймс Уотсон и Френсис Крик открыли двойную спираль ДНК 1955 - первая пересадка почки 1956 - первая коронарная ангиопластика 1961 - Маршалл Ниренберг расшифровал генетический код 1961 - первые пересадки гематогенных стволовых клеток для спасения обреченных пациентов 1964 - Чарлз Яновский подтвердил линейное соответствие генов и белков бактерий 1967 - первая пересадка сердца и печени 1969 - группа исследователей из Гарвардской медицинской школы изолировала первый ген человека 1974 - Стенли Коэн и Герберт Бойер пересадили ген лягушки в бактериальную клетку. Начало генной инженерии 1976 - создана первая биотехнологическая компания Genentech; начались пересадки генов человека в клетки микроорганизмов для промышленной наработки инсулина, интерферона и других полезных белков 1980 - Мартин Кляйн создал первую трансгенную мышь путем пересадки гена человека в оплодотворенную яйцеклетку мыши 1982 - генно-инженерный инсулин, наработанный бактериями, разрешен для использования в медицине 1983 - открыта полимеразная цепная реакция (техника многократного клонирования коротких цепей ДНК) - стало возможным синхронно изучать работу многих генов 1985 - техника "генетической дактилоскопии" ДНК стала использоваться в мировой криминалистике 1985 - первые пересадки фетальной нервной ткани для лечения болезни Паркинсона 1988 - выдан первый патент на генетически модифицированное животное 1990 - начало работ по международному проекту Геном Человека 1997 - клонировано первое млекопитающее - овца по кличке Долли; затем последовали удачные эксперименты по клонированию мышей и других млекопитающих 1997 -1998 - изолирование эмбриональных стволовых клеток человека в виде бессмертных линий 1998 - создание методов одновременной регистрации активности 1000 -2000 генов в геноме человека и млекопитающих 1999 -2000 - полная расшифровка генома 10 бактерий, дрожжей.
• • • • • • • • История важнейших открытий 1901 - Ландштейнер открыл группы крови, начало переливания крови 1906 - первая пересадка трупной роговицы 1910 - Томас Морган открыл хромосомы - органеллы наследственности 1926 - Меллер открыл мутагенные эффекты радиации и химических веществ 1912 - Бантинг и Бест открыли инсулин и причину диабета 1936 - первые ферменты получены в кристаллическом состоянии 1944 - Осваль Эвери и Маклин Мак. Карти доказали, что изолированная ДНК встраивается в геном бактерий, изменяя их фенотип 1904 - Нобелевская премия в области физиологии и медицины присуждена Ивану Петровичу Павлову за открытие условных рефлексов 1951 - первая операция коронарного шунтирования (коронарный байпасс) 1953 - Джеймс Уотсон и Френсис Крик открыли двойную спираль ДНК 1955 - первая пересадка почки 1956 - первая коронарная ангиопластика 1961 - Маршалл Ниренберг расшифровал генетический код 1961 - первые пересадки гематогенных стволовых клеток для спасения обреченных пациентов 1964 - Чарлз Яновский подтвердил линейное соответствие генов и белков бактерий 1967 - первая пересадка сердца и печени 1969 - группа исследователей из Гарвардской медицинской школы изолировала первый ген человека 1974 - Стенли Коэн и Герберт Бойер пересадили ген лягушки в бактериальную клетку. Начало генной инженерии 1976 - создана первая биотехнологическая компания Genentech; начались пересадки генов человека в клетки микроорганизмов для промышленной наработки инсулина, интерферона и других полезных белков 1980 - Мартин Кляйн создал первую трансгенную мышь путем пересадки гена человека в оплодотворенную яйцеклетку мыши 1982 - генно-инженерный инсулин, наработанный бактериями, разрешен для использования в медицине 1983 - открыта полимеразная цепная реакция (техника многократного клонирования коротких цепей ДНК) - стало возможным синхронно изучать работу многих генов 1985 - техника "генетической дактилоскопии" ДНК стала использоваться в мировой криминалистике 1985 - первые пересадки фетальной нервной ткани для лечения болезни Паркинсона 1988 - выдан первый патент на генетически модифицированное животное 1990 - начало работ по международному проекту Геном Человека 1997 - клонировано первое млекопитающее - овца по кличке Долли; затем последовали удачные эксперименты по клонированию мышей и других млекопитающих 1997 -1998 - изолирование эмбриональных стволовых клеток человека в виде бессмертных линий 1998 - создание методов одновременной регистрации активности 1000 -2000 генов в геноме человека и млекопитающих 1999 -2000 - полная расшифровка генома 10 бактерий, дрожжей.


